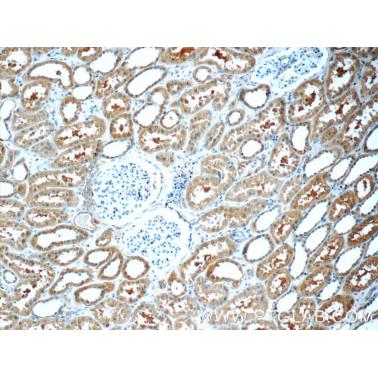

- 商品名称:免疫组织化学(IHC)技术服务
- 商品编号:JIHC
- 品牌:GoldenGene
- 上架时间:2019-07-20
- 商品毛重:0克
- 库存:
1000 台
服务承诺:
商城向您保证所售商品均为正品行货,商城自营商品自带机打发票,与商品一起寄送。凭质保证书及商城发票,可享受全国联保服务(奢侈品、钟表除外;奢侈品、钟表由商城联系保修,享受法定三包售后服务),与您亲临商场选购的商品享受相同的质量保证。商城还为您提供具有竞争力的商品价格和运费政策,请您放心购买!
注:因厂家会在没有任何提前通知的情况下更改产品包装、产地或者一些附件,本司不能确保客户收到的货物与商城图片、产地、附件说明完全一致。只能确保为原厂正货!并且保证与当时市场上同样主流新品一致。若本商城没有及时更新,请大家谅解!
权利声明:
商城上的所有商品信息、客户评价、商品咨询、网友讨论等内容,是商城重要的经营资源,未经许可,禁止非法转载使用。
注:本站商品信息均来自于厂商,其真实性、准确性和合法性由信息拥有者(厂商)负责。本站不提供任何保证,并不承担任何法律责任。
服务承诺:
商城向您保证所售商品均为正品行货,商城自营商品自带机打发票,与商品一起寄送。凭质保证书及商城发票,可享受全国联保服务(奢侈品、钟表除外;奢侈品、钟表由商城联系保修,享受法定三包售后服务),与您亲临商场选购的商品享受相同的质量保证。商城还为您提供具有竞争力的商品价格和运费政策,请您放心购买!
注:因厂家会在没有任何提前通知的情况下更改产品包装、产地或者一些附件,本司不能确保客户收到的货物与商城图片、产地、附件说明完全一致。只能确保为原厂正货!并且保证与当时市场上同样主流新品一致。若本商城没有及时更新,请大家谅解!
权利声明:
商城上的所有商品信息、客户评价、商品咨询、网友讨论等内容,是商城重要的经营资源,未经许可,禁止非法转载使用。
注:本站商品信息均来自于厂商,其真实性、准确性和合法性由信息拥有者(厂商)负责。本站不提供任何保证,并不承担任何法律责任。
服务承诺:
商城向您保证所售商品均为正品行货,商城自营商品自带机打发票,与商品一起寄送。凭质保证书及商城发票,可享受全国联保服务(奢侈品、钟表除外;奢侈品、钟表由商城联系保修,享受法定三包售后服务),与您亲临商场选购的商品享受相同的质量保证。商城还为您提供具有竞争力的商品价格和运费政策,请您放心购买!
注:因厂家会在没有任何提前通知的情况下更改产品包装、产地或者一些附件,本司不能确保客户收到的货物与商城图片、产地、附件说明完全一致。只能确保为原厂正货!并且保证与当时市场上同样主流新品一致。若本商城没有及时更新,请大家谅解!
权利声明:
商城上的所有商品信息、客户评价、商品咨询、网友讨论等内容,是商城重要的经营资源,未经许可,禁止非法转载使用。
注:本站商品信息均来自于厂商,其真实性、准确性和合法性由信息拥有者(厂商)负责。本站不提供任何保证,并不承担任何法律责任。

京公网安备 11010802034257号
京公网安备 11010802034257号